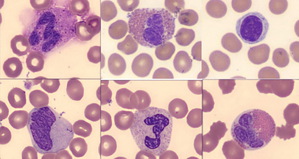

長庚紀念醫院使用在NVIDIA DGX 與 Pure Storage FlashBlade 上打造的工具,將人工智慧用於顯微鏡檢查作業當中。醫生可以從驗血結果得知重大器官的運作情況及發現各種醫療狀況,包括心臟病、貧血和癌症。在每間大型醫院都有著成堆的血細胞影像等著進行分析。
|
| 人工智慧加快台灣最大醫院分析血細胞的速度 |
擁有超過一萬個床位、每年看診人數達八百萬人以上,台灣的長庚紀念醫院每年收集至少一百萬個血細胞影像。長庚醫院的臨床醫生必須隨時待命,血液分析是急診科的頭等大事。為了提高效率和準確性,全台共有七處分院的長庚醫療體系採用在「AIRI」(AI-Ready 基礎架構)上開發的深度學習工具。
由 Pure Storage 與 NVIDIA 合作開發出的 AIRI 架構,以 NVIDIA DGX POD 參考設計框架為基礎,並且由 NVIDIA DGX-1 與 Pure Storage FlashBlade 共同提供支援。長庚醫院的 AIRI 解決方案搭載了四套 NVIDIA DGX-1 系統,各系統的人工智慧運算效能達到 1 petaflop。各 DGX-1 系統又搭載了八個全球速度最快的資料中心加速器,也就是 NVIDIA V100 Tensor Core GPU。
長庚紀念醫院當前的血細胞分析工具能夠自動分辨五大類白細胞,不過醫生還是得以人工方式去辨識其他種類的細胞,而這是一件相當勞民傷財的事。
該院開發出的深度學習模型提供了更全面的分析,能夠從顯微鏡影像中分類出十八種血細胞,準確率達 99%。擁有一項能夠分辨多種血細胞的人工智慧工具,還能提高醫生對罕見細胞類型進行分類的能力,進而提高疾病診斷的準確性。使用人工智慧可以在不影響測試品質的情況下,減少臨床醫生的工作量。
長庚紀念醫院靠著 AIRI 的整合式基礎架構設計,整合了運算、網路、儲存、電源和冷卻等方面的最佳實踐內容,以求加快其深度學習模型的訓練及推論速度。
人工智慧檢測長庚醫院的血液樣本
在對患者完成抽血後,長庚紀念醫院使用自動化工具對血液進行採樣,然後將血液樣本塗在顯微鏡載玻片上並進行染色,以便檢查紅細胞、白細胞和血小板。接著機器會拍攝載玻片的影像,也就是所謂的血液塗片,如此便能使用演算法對其進行分析。
長庚紀念醫院使用遷移學習技術,在 AIRI 架構上使用擁有六萬個血細胞影像的資料集來訓練卷積神經網路。人工智慧靠著一架搭載 NVIDIA T4 GPU 的伺服器,只要兩秒鐘就能解讀一組25個影像並進行推論,這個動作比尋常一組三名醫學專家要花上五分鐘才能完成解讀的速度快上一百倍。
深度學習除了能更快提出血液測試的結果,還能減輕醫師的工作疲勞及提高血細胞分析的品質。長庚紀念醫院醫療人工智能核心實驗室主任郭昶甫表示,人工智慧解決了兩大問題,將改善整個醫療診斷過程,尤其是醫病關係。這兩大問題分別是時間方面的限制與人力資源成本。
部分血細胞類型極為罕見,造成訓練資料集呈現失衡狀態。為了增加罕見細胞類型的範例影像數量及增進模型的表現,研究人員正在使用生成對抗網路(GANs)進行實驗。
長庚醫院還將 AIRI 用在骨折影像辨識、基因組學及免疫螢光項目上。目前的人工智慧工具側重於辨識身體病況,未來或許可以用在預測疾病上。

